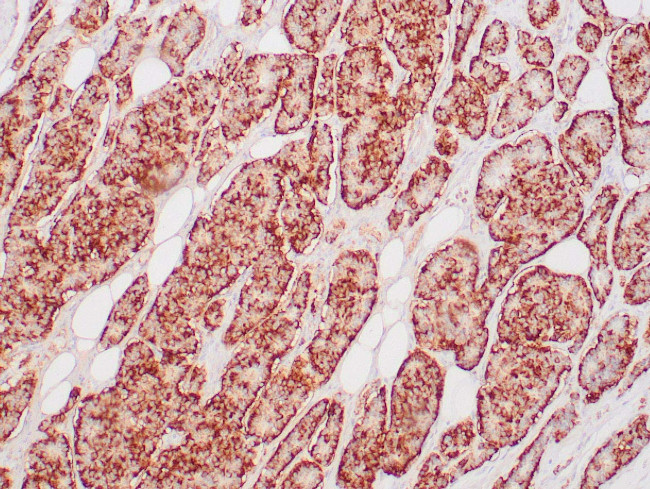
Chromogranin A Antibody in Immunohistochemistry (Paraffin) (IHC (P))

Search
Zeta
Chromogranin A Monoclonal Antibody (ZM12), MonoMab™
{{$productOrderCtrl.translations['antibody.pdp.commerceCard.promotion.promotions']}}
{{$productOrderCtrl.translations['antibody.pdp.commerceCard.promotion.viewpromo']}}
{{$productOrderCtrl.translations['antibody.pdp.commerceCard.promotion.promocode']}}: {{promo.promoCode}} {{promo.promoTitle}} {{promo.promoDescription}}. {{$productOrderCtrl.translations['antibody.pdp.commerceCard.promotion.learnmore']}}
产品信息
Z2347MP
种属反应
宿主/亚型
分类
类型
克隆号
抗原
偶联物
形式
纯化类型
保存液
内含物
保存条件
运输条件
产品详细信息
This product is diluted and in a ready-to-use formulation.
A recommended positive control tissue for this product is Pancreas, however positive controls are not limited to this tissue type.
The primary antibody is intended for laboratory professional use in the detection of the corresponding protein in formalin-fixed, paraffin-embedded tissue stained in manual qualitative immunohistochemistry (IHC) testing. This antibody is intended to be used after the primary diagnosis of tumor has been made by conventional histopathology using non-immunological histochemical stains.
Chromogranin A is present in neuroendocrine cells throughout the body, including the neuroendocrine cells of the large and small intestine, adrenal medulla and pancreatic islets. It is an excellent marker for carcinoid tumors, pheochromocytomas, paragangliomas, and other neuroendocrine tumors. Co-expression of chromogranin A and neuron specific enolase (NSE) is common in neuroendocrine neoplasms. Reportedly, co-expression of certain keratins and chromogranin indicates neuroendocrine lineage. The presence of strong anti-chromogranin staining, and absence of anti-keratin staining should raise the possibility of paraganglioma. The co-expression of chromogranin and NSE is typical of neuroendocrine neoplasms. Most pituitary adenomas and prolactinomas readily express chromogranin.
Antibody is used with formalin-fixed and paraffin-embedded sections. Pretreatment of deparaffinized tissue with heat-induced epitope retrieval or enzymatic retrieval is recommended. In general, immunohistochemical (IHC) staining techniques allow for the visualization of antigens via the sequential application of a specific antibody to the antigen (primary antibody), a secondary antibody to the primary antibody (link antibody), an enzyme complex and a chromogenic substrate with interposed washing steps. The enzymatic activation of the chromogen results in a visible reaction product at the antigen site. Results are interpreted using a light microscope and aid in the differential diagnosis of pathophysiological processes, which may or may not be associated with a particular antigen.
A positive tissue control must be run with every staining procedure performed. This tissue may contain both positive and negative staining cells or tissue components and serve as both the positive and negative control tissue. External Positive control materials should be fresh autopsy/biopsy/surgical specimens fixed, processed and embedded as soon as possible in the same manner as the patient sample (s). Positive tissue controls are indicative of correctly prepared tissues and proper staining methods. The tissues used for the external positive control materials should be selected from the patient specimens with well-characterized low levels of the positive target activity that gives weak positive staining. The low level of positivity for external positive controls is designed to ensure detection of subtle changes in the primary antibody sensitivity from instability or problems with the staining methodology. A tissue with weak positive staining is more suitable for optimal quality control and for detecting minor levels of reagent degradation.
Internal or external negative control tissue may be used depending on the guidelines and policies that govern the organization to which the end user belongs to. The variety of cell types present in many tissue sections offers internal negative control sites, but this should be verified by the user. The components that do not stain should demonstrate the absence of specific staining, and provide an indication of non-specific background staining. If specific staining occurs in the negative tissue control sites, results with the patient specimens must be considered invalid.
靶标信息
Chromogranin A (CHGA) is a member of the chromogranin/secretogranin family of neuroendocrine secretory proteins. It is found in secretory vesicles of neurons and endocine cells. CHGA is a precursor to three biologically active peptides: vasostatin, pancreastatin, and parastatin. These peptides act as autocine or paracrine negative modulators of the neuroendocrine system. CHGA is an excellent marker for carcinoid tumors, pheo-chromocytomas, paragangliomas, and other neuro-endocrine tumors. Coexpression of chromogranin A and neuron specific enolase (NSE) is common in neuroendocrine neoplasms.
仅用于科研。不用于诊断过程。未经明确授权不得转售。
篇参考文献 (0)
生物信息学
蛋白别名: betagranin (N-terminal fragment of chromogranin A); catestatin; CgA; chromofungin; Chromogranin-A; CTNNB; DKFZp686D02253; FLJ25606; FLJ37923; MGC105435; parathyroid secretory protein 1; Pituitary secretory protein I; SP-I
基因别名: CGA; CHGA
UniProt ID: (Human) Q9BQB5
Entrez Gene ID: (Human) 1113